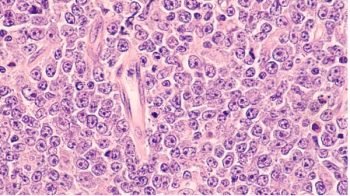

The oral medication activates an “anti-hunger” molecule which may prevent people from overeating.
Erin Hunter is an assistant editor at Pharmacy Times®. She is a proud alumna of the University of Massachusetts. She graduated with degrees in Journalism, Art History, and Environmental Conservation.

The oral medication activates an “anti-hunger” molecule which may prevent people from overeating.

Their expansive scope of services can ultimately help to elevate the work of the entire community pharmacy.

Menopause can have severe repercussions on female health which impact quality of life and health span, according to an expert of women’s health.

The FDA assigned a Prescription Drug User Fee Act (PDUFA) goal date of October 8, 2024.

Nearly 75% of patients who had an initial complete response with mosunetuzumab maintained that complete response after 3 years.

New CAR T development method infuses immune T cells from healthy people into patients to improve outcomes.

The risk of poor cognitive performance was nearly double in participants who had the greatest number of sleep disturbances compared to the least.

However, cognitive performance was not significantly worse than patients hospitalized for other conditions of a similar severity.

Sleep duration is positively associated with quality of life in adolescents.

Patients who receive stimulation at different parts of the brain may reap benefits.

In the Augment-101 phase 2 study, 63% of patients experienced overall response rate with revumenib.
This therapeutic could work for diseases of the B cell receptor signaling transduction pathway that do not respond well to single-agent BTK inhibitor.

The CAR T-cell therapy improved relative overall survival by more than a third compared to standard of care.

Expert discusses positive, real-world findings from a claims-based study looking at this therapeutic.

The majority (86.7%) of patients in the study got less than 7 hours of sleep each night.

Investigators will evaluate prophylactic tocilizumab prior to treatment with teclistamab.

Although treatment is effective, AEs remain difficult for patients.

Moderate cycling improved cognitive function in patients who got partial or no sleep.

Feldman, who previously had C. diff, urges individuals to begin having conversations to help remove the stigma of the disease and raise awareness of its prevalence.

Feldman details her experience with C. diff, how the COVID-19 pandemic slowed the timeline of care, and how her surgical history and the use of antibiotics played into the disease’s onset.

There is progress being made regarding research on immunotherapies and the mutation, which adversely affects a higher number of patients in this population.

In a recent study, people who lived in disadvantaged or rural areas were just as likely to receive the second-generation medications as people in urban areas.

However, a survival benefit was observed with using a signaling inhibitor in general for patients with angioimmunoblastic T-cell lymphoma.

The pharmacist can help patients to manage symptoms throughout the entire treatment journey.

Expert breaks down these findings and more from the GLAMM1 study at the 2023 ASH Annual Meeting.

Only 20% of the patient population were reported as being “very good” sleepers when it comes to sleep disturbances.

The bacteria were shown to contain a membrane-bound organelle structure that is like those found in eukaryotic cells.

Median overall survival is set to be more than 2 years, which is more than double the overall survival of current frontline therapies.

He also provides insight for students training in classical hematology, oncology hematology, or oncology pharmacy.

The president highlights a new curative treatment option for sickle cell disease while also expanding on the changing treatment landscape for hematologic conditions.

Published: October 17th 2022 | Updated:

Published: January 24th 2023 | Updated:

Published: December 8th 2023 | Updated:

Published: January 24th 2023 | Updated:

Published: October 3rd 2022 | Updated:

Published: September 12th 2023 | Updated: